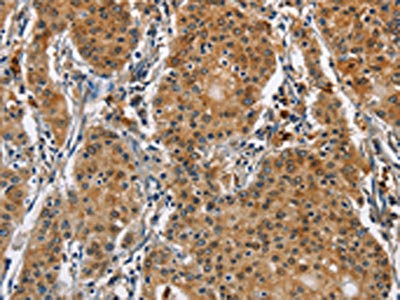

CAT Antibody
-
中文名稱:CAT兔多克隆抗體
-
貨號:CSB-PA942303
-
規格:¥1100
-
圖片:
-
The image on the left is immunohistochemistry of paraffin-embedded Human ovarian cancer tissue using CSB-PA942303(CAT Antibody) at dilution 1/40, on the right is treated with fusion protein. (Original magnification: ×200)
-
The image on the left is immunohistochemistry of paraffin-embedded Human gastric cancer tissue using CSB-PA942303(CAT Antibody) at dilution 1/40, on the right is treated with fusion protein. (Original magnification: ×200)
-
Gel: 8%SDS-PAGE, Lysate: 40 μg, Lane: Hela cells, Primary antibody: CSB-PA942303(CAT Antibody) at dilution 1/300, Secondary antibody: Goat anti rabbit IgG at 1/8000 dilution, Exposure time: 3 minutes
-
-
其他:
產品詳情
-
Uniprot No.:
-
基因名:
-
別名:Cas1 antibody; CAT antibody; CATA_HUMAN antibody; Catalase antibody; Cs1 antibody; MGC138422 antibody; MGC138424 antibody
-
宿主:Rabbit
-
反應種屬:Human,Mouse,Rat
-
免疫原:Fusion protein of Human CAT
-
免疫原種屬:Homo sapiens (Human)
-
標記方式:Non-conjugated
-
抗體亞型:IgG
-
純化方式:Antigen affinity purification
-
濃度:It differs from different batches. Please contact us to confirm it.
-
保存緩沖液:-20°C, pH7.4 PBS, 0.05% NaN3, 40% Glycerol
-
產品提供形式:Liquid
-
應用范圍:ELISA,WB,IHC
-
推薦稀釋比:
Application Recommended Dilution ELISA 1:1000-1:2000 WB 1:200-1:1000 IHC 1:50-1:200 -
Protocols:
-
儲存條件:Upon receipt, store at -20°C or -80°C. Avoid repeated freeze.
-
貨期:Basically, we can dispatch the products out in 1-3 working days after receiving your orders. Delivery time maybe differs from different purchasing way or location, please kindly consult your local distributors for specific delivery time.
-
用途:For Research Use Only. Not for use in diagnostic or therapeutic procedures.
相關產品
靶點詳情
-
功能:Occurs in almost all aerobically respiring organisms and serves to protect cells from the toxic effects of hydrogen peroxide. Promotes growth of cells including T-cells, B-cells, myeloid leukemia cells, melanoma cells, mastocytoma cells and normal and transformed fibroblast cells.
-
基因功能參考文獻:
- 'T' allele of C262T showed a protective effect against the risk of ovarian cancer PMID: 29421935
- There was no significant association between the CAT gene SNP rs1001179 and Type 1 Diabetes or Diabetic Peripheral Neuropathy. PMID: 29924645
- Low CAT expression is associated with childhood obesity. PMID: 29953407
- CAT rs769218 GG was associated with poor overall survival compared to GA/AA genotypes in patients without platinum and fluorouracil-based adjuvant chemotherapy. PMID: 30114685
- homocysteine reacts with native catalase and/or redox-active transition metal ions to generate thiyl radicals that mediate compound II formation, a temporarily inactive state of the enzyme. PMID: 27848965
- Data suggest catalase (CAT) rs769214 (-844 G > A) polymorphism may be associated with N,N-dimethylacetamide (DMAc)-induced abnormal liver function in Chinese population. PMID: 28749186
- Maternal catalase activity was found to be lower in neural tube defect-affected pregnancies as compared to healthy controls. PMID: 28397206
- Catalase SNPs (C-262T and A-21T) show positive correlation in the model of SNP-SNP interaction in systemic lupus erythematosus. PMID: 28711952
- Study identifies an association of the polymorphism of CAT -262C/T in the Algerian population with type 1 diabetes without complications. PMID: 29859283
- Findings suggest that gene-environment interactions between the catalase polymorphism rs769214 and mold odor may play an important role in childhood allergic rhinitis development. PMID: 29028686
- catalase gene polymorphisms (rs1001179 and rs794316) have roles in cancer susceptibility [meta-analysis] PMID: 27449288
- the association between the different Catalase -262C/T genotypes and Catalase levels in seminal plasma and and male infertility PMID: 28436704
- This study showed that ADMA, carbonyl groups, CAT and NKA can be useful markers of chronic stress in both males and females with depression, PTSD, and depression concurrent with PTSD. PMID: 28554099
- The investigated MnSOD and Catalase polymorphisms do not predispose to the development of alcoholic Chronic Pancreatitis. PMID: 28655148
- the CAT C262T polymorphism may be a candidate markerfor cancer risk with type-specific and population-specific effects but not a fine prognostic factor for cancer survival. [meta-analysis] PMID: 27225983
- The CAT1 haplotype could be implicated in the level of metabolic and cardiovascular improvement after bariatric surgery. PMID: 29496557
- This study showed that CAT functional SNP rs769217 was significantly associated with primary open angle glaucoma (POAG), implying that the CAT gene variants may play a role in the pathogenesis of POAG in the Chinese population. PMID: 28829657
- By dividing patients into two groups, increased (P-I/R-I) and decreased TBARS (P-II/R-II) at T12 compared to T0, we found an increased CAT activity in conditioned endothelial cells at T12 in both groups (p=0.05 and p=0.001, respectively). PMID: 28652427
- research demonstrated that erysipelas infection predisposition and its clinical characteristics are affected by age, sex and SNPs found in SOD1, SOD2, and catalase genes; presence of SOD1 G7958, SOD2 T2734, and CAT C262 alleles was linked to erysipelas' predisposition PMID: 28512644
- A melanoma cell model with low levels of H2O2 induced by catalase overexpression to study differentiation/dedifferentiation processes. PMID: 27206672
- Gene expression microarrays in A375 melanoma cells with different ROS levels after overexpressing catalase were performed. Gene expression signature could be relevant in clinical prognostic to classify between non aggressive and metastatic melanomas. PMID: 27206673
- It has been shown that the AP-1 family member JunB and retinoic acid receptor alpha (RARa) mediate catalase transcriptional activation and repression, respectively, by controlling chromatin remodeling through a histone deacetylases-dependent mechanism. PMID: 27591797
- these findings lend credit to the idea that inefficient catalase import, when coupled with the role of PEX5 as a redox-regulated import receptor, constitutes a cellular defense mechanism to combat oxidative insults of extra-peroxisomal origin. PMID: 28760655
- our data suggest that gene polymorphisms of GPX1 Pro198Leu and CAT C262T may have a protective role in the development of primary open-angle glaucoma in a Polish population. PMID: 28547970
- Mutated obese carries of SOD1 -251, SOD2 47 and CAT -262 are associated with a higher distribution of fat in comparison with obese wild-type carriers. PMID: 27751366
- The present study determined that ARE, CLP, CAT, and MPO levels are different between the pediatric patients with sepsis and healthy controls. ARE level can be a potent biomarker for sepsis in critical patients in intensive care units. PMID: 28167245
- Conducted our audit should be extended to more group of patients in order to assess whether or not to confirm the observed during analysis, the protective effect of CAT-262 C / T in ulcerative colitis and other trends observed for other polymorphic variants tested genes. PMID: 28141554
- Superoxide dismutase and catalase activities were lower in type 1 myotonic dystrophy patients compared to healthy controls PMID: 26817806
- results suggest that, in dyslipidemic patients, the catalase rs1001179 TT genotype is associated with higher HbA1c and plasma triglyceride levels, and that these associations may be modulated by BMI and/or age PMID: 27704307
- Study demonstrates that SOD2 rs4880, GPX1 rs1050450 and CAT rs1001179 are not associated with an increased susceptibility to epilepsy after neonatal hypoxic-ischemic encephalopathyor its drug resistance PMID: 28222320
- The antioxidative effects of the Mediterranean diet against breast cancer risk may be enhanced by the wild-type alleles of the MnSOD or CAT SNPs among Greek-Cypriot women. PMID: 26130326
- The TT genotype distribution for the A/T polymorphism in catalase gene at position -21 was statistically significant differences in eosinophilic Chronic rhinosinusitis with nasal polyps and control groups. PMID: 27515707
- Genetic polymorphisms in eNOS, catalase and myeloperoxidase and their significance in a cohort of Turkish prostate cancer patients. PMID: 27706591
- Data show that selective and gradual inhibition of membrane-associated catalase of tumor cells or siRNA-mediated knockdown of the total catalase in tumor cells leads to an optimum curve of apoptosis induction. PMID: 28179303
- There were significant differences between catalase polymorphisms. The studied polymorphisms showed linkage disequilibrium. The mRNA levels of CAT in the AC/TT, TC/TC, TC/TT, and TC/TC diplotypes significantly were higher than the mRNA levels in AC/AC diplotype. PMID: 27225276
- CAT -844G>A (rs769214) polymorphism is associated with the development of Essential Hypertension in smokers. PMID: 27735913
- Study showed that endothelial cells from human umbilical vein have a reduced activity and gene expression of the "classic" antioxidant enzymes (Cu,Zn-superoxide dismutase, catalase, and Se-containing glutathione peroxidase). At the same time, a high expression level of peroxiredoxin genes was identified in the same endothelial cells PMID: 28058676
- The effects of oleuropein (OL) on hydrogen peroxide-induced oxidative stress in L02 cells showed that SOD1, GPx1, and catalase levels were all increased, and suggested that OL is a potent antioxidant and may be therapeutically useful in liver disease prevention. PMID: 27914828
- There were significant differences in the TT genotype distribution of the -21A>T polymorphism in the CAT gene between the tympanosclerosis and control groups, and between the chronic otitis media and control groups. PMID: 27534583
- The purpose of the study was to evaluate the plasma level of superoxide dismutase (SOD), catalase (CAT), and glutathione peroxidase (GPX) and the association between polymorphic variants in genes encoding for GPx1, SOD, CAT and the risk of distal symmetric polyneuropathy in type 2 diabetes mellitus patients. PMID: 26674569
- Among acute kidney injury patients in the Turkish population, hospital morbidity and mortality were found to be more frequent in patients bearing a T allele of the rs769217 polymorphism of the CAT gene. PMID: 26787049
- This study indicates that catalase C-262T polymorphism is associated with the endometriosis. PMID: 25154023
- Our results suggest that 389C>T may not contribute to vitiligo susceptibility. PMID: 25139332
- CAT rs1001179 polymorphism could be used to identify children that have a higher susceptibility to cerebral palsy after perinatal Hypoxic-ischaemic perinatal brain injury PMID: 27302388
- Increasing the endogenous NO level causes catalase inactivation and reactivation of intercellular apoptosis signaling specifically in tumor cells. PMID: 26342455
- In patients with chronic hepatitis C, the GPX1 Pro198Leu polymorphism, alone or combined with the CAT C-262T, was associated with high risk of fibrosis severity and hepatocellular carcinoma (HCC). In addition, GPX1 polymorphism was also associated with advanced stages of HCC. PMID: 26990426
- Deciphering the molecular mechanisms that regulate catalase expression could, therefore, be of crucial importance for the future development of pro-oxidant cancer chemotherapy. PMID: 26117330
- Study shows that the SOD2 16C/T and CAT -21A/T alleles may serve as useful genetic susceptibility markers for migraine PMID: 25818327
- the ratios SOD2/catalase and SOD2/Gpx1 could be considered as potential markers during progression from tumor growth to metastasis PMID: 25866291
- This study identified CAT is a Noise-induced hearing loss susceptibility gene when noise exposure levels are taken into account. PMID: 26045794
顯示更多
收起更多
-
相關疾病:Acatalasemia (ACATLAS)
-
亞細胞定位:Peroxisome.
-
蛋白家族:Catalase family
-
數據庫鏈接:
Most popular with customers
-
-
YWHAB Recombinant Monoclonal Antibody
Applications: ELISA, WB, IHC, IF, FC
Species Reactivity: Human, Mouse, Rat
-
-
-
-
-
-